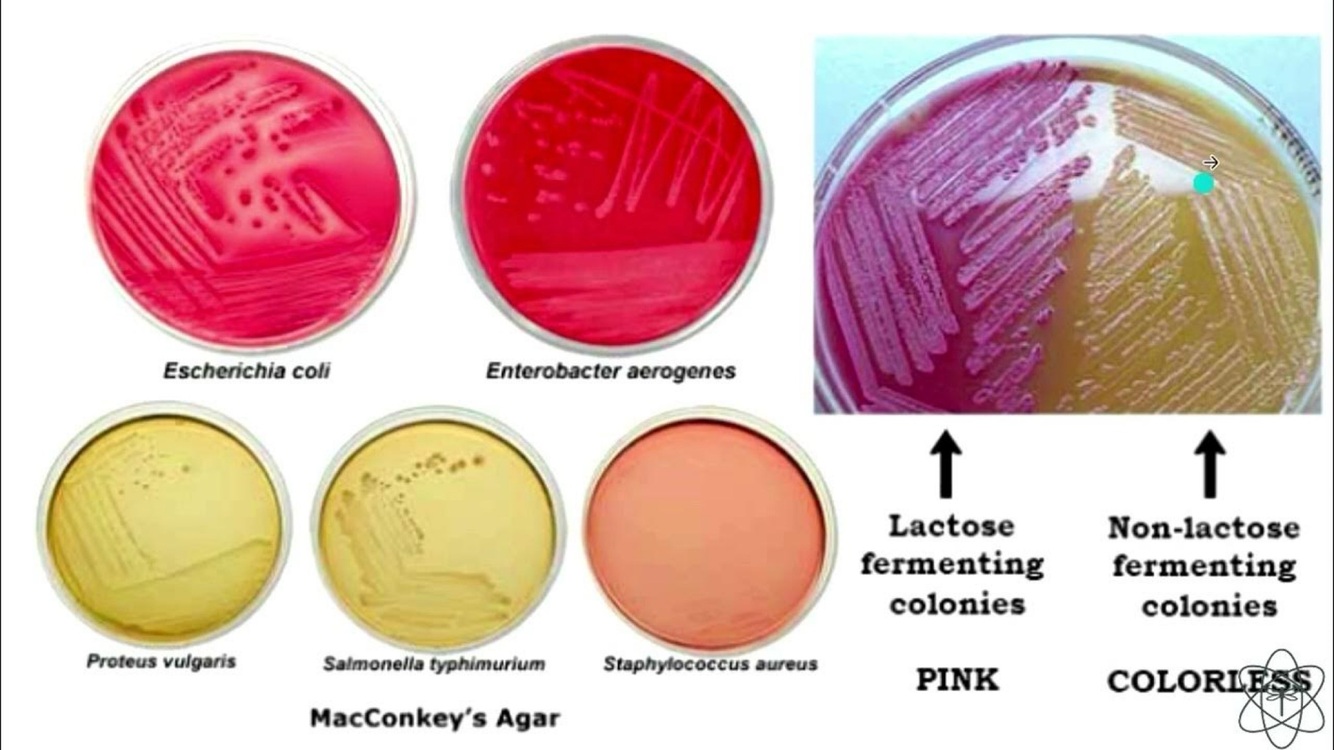

Cómo se dividen las enterobacterias ?
Patógenos primarios → bacterias lo suficientemente patogénicas para producir la enfermedad
Patógenos secundarios → bacterias que únicamente pueden causar la enfermedad sobre ciertas condiciones o huéspedes
Características generales de las enterobacterias
- ubicuos, saprofitos (viven en todos lados)
- forman parte de la microbiota intestinal
- Son bacterias cada vez mas resistentes
- Causa la mayoría de las IVU’s, gastroenteritis bacterianas
- Principal causa de infecciones asociadas a cuidados de salud en México
- GRAN capacidad de adquisición de mecanismos de resistencia
- Zoonosis, antropologías y endógenas
Características microbiológicas de las enterobacterias
- BGN
- Forma de “caja”
- NO forman esporas
- Anaerobios facultativos
- La mayoría son móviles
- Son fermentadores de glucosa y oxidasa negativos
- LPS de la pared celular
Qué enterobacterias NO forman parte de nuestra microbiota intestinal ?
- Salmonella, Shigella, Yersinia
- NO forman parte de nuestra microbiota!!!!
Cuál es el Agar selectivo y diferencial
Agar Mac Conkey
- crecimiento selectivo para BGN (inhibe crecimiento de G+)
- Diferencia los fermentadores de lactosa y no fermentadores de lactosa por medio de color
- Morado/rosa → bacteria que sí es fermentadora de lactosa
Determinantes de virulencia de las enterobacterias
- actividad endotoxina del LPS
- cápsula: inhibe fagocitosis
- variaciones antigénicas (antígeno K y H): vs. inmunidad por anticuerpos
- Plasticidad genética
- Sistemas de secreción tipo III: traspasar factores de virulencia de las células
Características microbiológicas de E.Coli
- aerobio + frecuente del TGI
- Expresan adhesinas y secretan exotoxinas
Gastroenteritis por E. Coli del intestino delgado
- Diarreas secretoras/acuosas
- Más frecuentes en niños y en países en desarrollo, en ocasiones en brotes
- ECET
- ECEP
- ECEA
Enterotoxigénica (ECET)
Enterotoxinas termolábiles y termoestables incrementan AMPc, secretan mucho cloro y por lo tanto hay mucha diarrea “Diarrea del viajero”
Enteropatogénica (ECEP)
Adhesión y destrucción de las vellosidades
Enteroagregativa (ECEA)
- se adhieren entre ellas por medio de sus fimbrias y secreción de moco y forman entre ellas colonias
- Pueden secretar toxinas termoestables
Gastroenteritis por E. Coli del intestino grueso
- Más frecuentes en países desarrollados
- Diarreas invasoras/sanguineolentas
- ECEH
- ECEI
Enterohemorrágica (ECEH)
- Borramiento de vellosidades
- Colitis hemorrágica
- Cepa CO157:H7: causante del SHU (síndrome hemolÍtico urémico) común en niños, productora de toxina tipo Shiga (inhibe la síntesis de proteínas en todo el cuerpo)
Enteroinvasiva (ECEI)
- Invaden y destruyen epitelio
- Diarrea acuosa que progresa a disentería
Cuadros extraintestinales
- Uropatogénicas (ECUP)
- Bacteriemia y neumonía asociada a ventilador (ECAS)
- Meningitis (ECMN)
Uropatogénicas (ECUP)
- adhesinas → las mantiene muy muy pegadas al epitelio urinario
- 80-90% de las IU
Bacteriemia y Neumonía asociada a ventilador (ECAS)
- mal lavado de manos
- Bacterias lleguen a sitios donde normalmente NO estaban.
- infecciones endógenas secundarias a sepsis abdominal o urosepsis
- ALTA mortalidad y resistencia a los antibióticos
Meningitis (ECMN)
- predominio en los RN
- antígeno capsular K1
Características microbiológicas de Klebsiella spp
- Cápsula prominente: colonias mucosas en MAC
- Las colonias son MUY mucosas y se empiezan a fusionar entre ellas
- Moco pegajoso que no se despega tan fácilmente
Klebsiella pneumoniae
- 2da causa + frecuente de IVU
- Causa frecuente de neumonías y bacteriemias asociadas a cuidados de salud
- Pueden causar neumonías en la comunidad
- Principal factor de riesgo: alcoholismo
Klebsiella granulomatis

- ETS
- Granuloma inguinal - úlceras en la zona anal
- (Donovanosis)
- 1al en África
Características microbiológicas de la Salmonella spp
- BGN
- Anaerobios facultativos
- No forman microbiota
- Invaden enterocitos y pasan a la circulación
- Clasificaciones + complejas: expresa 3 tipos de antígenos de superficie y cada uno de ellos tiene muchas variaciones (O, Vi, H)
Las especies que afectan humanos resisten la bilis
Cuáles son los animales más frecuentes qué ocasionan la salmonella ?

Pollos y gallinas
- La salmonella vive en el interior del intestino de los gallinas
- El interior de los huevos puede estar contaminado, puede tener a las bacterias. El consumo del huevo crudo, es un factor de riesgo
Gastroenteritis por Salmonella
- Náusea y vómito
- Diarrea no sanguinolenta
- Fiebre, mialgias




